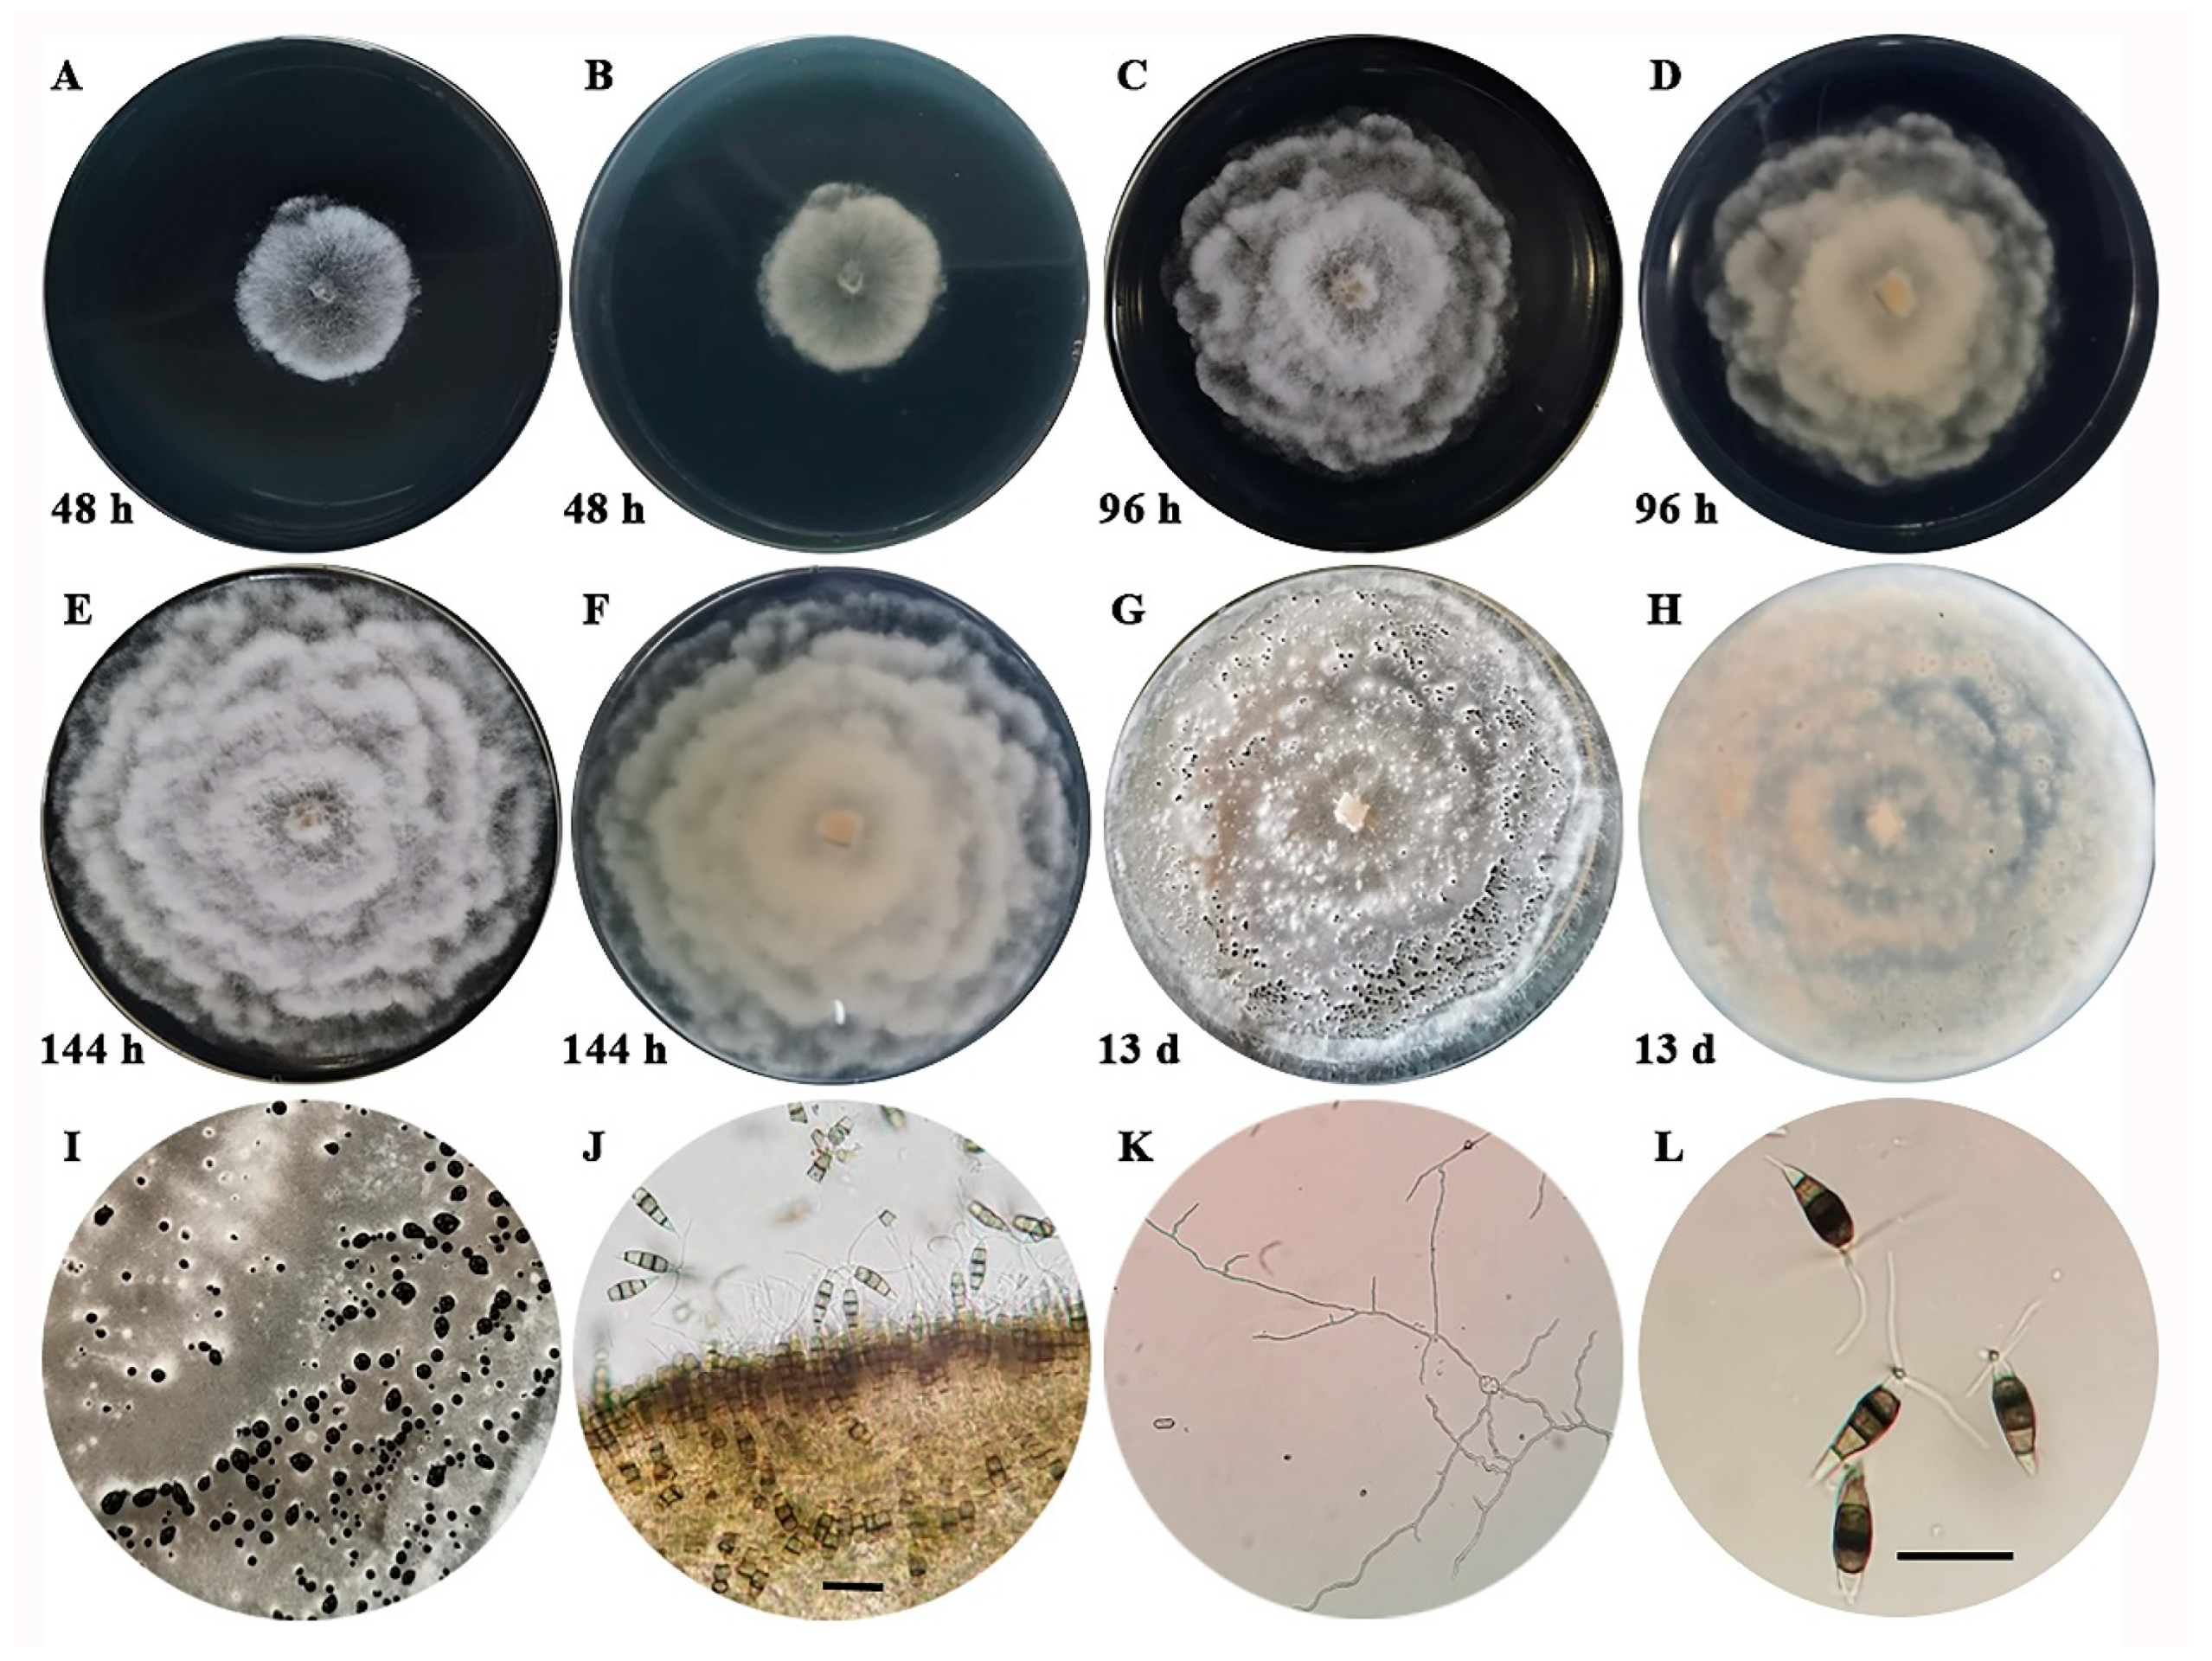
Agronomy 14 01658 g002

Occurrence of Neopestalotiopsis clavispora Causing Apple Leaf Spot in China
Abstract
:1. Introduction
2. Materials and Methods
2.1. Collection of Samples and Inoculation Materials
2.2. Isolation of Fungal Pathogens
2.3. Morphological Identification of Pathogen
2.4. Molecular Identification and Phylogenetic Analysis
2.5. Pathogenicity Tests
2.6. Host Range Tests
2.7. Toxicity Determination of Ten Fungicides
2.8. Data Analysis
3. Results
3.1. The Field Disease Symptoms
3.2. Pathogen Isolation and Morphological Characteristics
3.3. Molecular Identification of the Pathogen
3.4. Pathogenicity Tests
3.5. Host Range Test of the Pathogen
3.6. Toxicity Determination of Ten Fungicides on Neopestalotiopsis clavispora
4. Discussion
5. Conclusions
Author Contributions
Funding
Data Availability Statement
Conflicts of Interest
References
- Ritchie, H.; Roser, M. Agricultural Production. Our World in Data. Available online: https://ourworldindata.org/agricultural-production (accessed on 22 July 2022).
- Yu, H.N.; Bai, N.; Wang, G.; Guo, D.T.; Zhang, L.L. Current situation and countermeasures of apple processing industry in Yantai city. China Fruit Veg. 2023, 43, 80–84. [Google Scholar]
- Zhang, X.Q.; Li, D.M.; Liu, X.; Sun, T.; Lin, X.J.; Ren, Z.H. Research of segmentation recognition of small disease spots on apple leaves based on hybrid loss function and CBAM. Front. Plant Sci. 2023, 14, 1175027. [Google Scholar] [CrossRef]
- Deng, X.; Chen, Y.; Ma, Z.L.; Huang, X.M. Discovery of a new pathogen in early leaf falling disease of Zhaotong apple. South China Fruits 2021, 50, 124–129. [Google Scholar]
- Wang, K.; Liu, F.; Cai, L. A name list of common agricultural phytopathogenic fungi in China. Mycosystema 2022, 41, 361–386. [Google Scholar]
- Crous, P.W.; Rossman, A.Y.; Aime, C.; Allen, C.; Burgess, T.; Groenewald, J.Z.; Castlebury, L. Names of phytopathogenic fungi: A practical guide. Phytopathology 2021, 111, 1500–1508. [Google Scholar] [CrossRef] [PubMed]
- Maharachchikumbura, S.S.N.; Hyde, K.D.; Groenewald, J.Z. Pestalotiopsis revisited. Stud. Mycol. 2014, 79, 121–186. [Google Scholar] [CrossRef]
- Tejesvi, M.V.; Tamhankar, S.A.; Kini, K.R. Phylogenetic analysis of endophytic Pestalotiopsis species from ethnopharmaceutically important medicinal trees. Fungal Divers. 2009, 38, 167–183. [Google Scholar]
- Keith, L.M.; Velasquez, M.E.; Zee, F.T. Identification and characterization of Pestalotiopsis spp. causing scab disease of guava, Psidium guajava, in Hawaii. Plant Dis. 2006, 90, 16–23. [Google Scholar] [CrossRef]
- Jeewon, R.; Liew EC, Y.; Simpson, J.A. Phylogenetic significance of morphological characters in the taxonomy of Pestalotiopsis species. Mol. Phylogenetics Evol. 2003, 27, 372–383. [Google Scholar] [CrossRef]
- Prasannath, K.; Shivas, R.G.; Galea, V.J.; Akinsanmi, O.A. Neopestalotiopsis species associated with flower diseases of Macadamia integrifolia in Australia. J. Fungi 2021, 7, 771. [Google Scholar] [CrossRef]
- Yi, J.P.; Liang, W.S.; Zhou, G.L.; Ye, J.; Yin, L.P.; Qiu, S.H.; Zhou, E.X. Identification of Pestalotiopsis sp. from imported American apple. Plant Quar. 2006, 5, 269–271. [Google Scholar]
- Xu, X.H. Investigation on the Occurrence and Control of Apple Pests and Diseases in Yantai Area. Master’s Thesis, Shandong Agricultural University, Tai’an, China, 2019; pp. 41–50. [Google Scholar]
- Choi, Y.W.; Hyde, K.D.; Ho, W.H. Single spore isolation of fungi. Fungal Divers. 1999, 3, 29–38. [Google Scholar]
- Zhang, H.; Zhang, Z.; Xu, J.S.; Xu, J.; Zhang, L.P.; Pan, Z.C.; Tian, Q.; Feng, J. A rapid and simple method for obtaining single-spore isolates of Fusarium species-agar dilution lineation separation. Plant Prot. 2008, 34, 134–136. [Google Scholar]
- Lu, J.Y. Chapter XVII, Deuteromycotina (part 2), Coelomycetes. In Plant Pathogenic Mycology; Bai, J.K., Lui, G.Z., Liang, J.Y., Eds.; China Agriculture Press: Beijing, China, 2001; pp. 474–475. [Google Scholar]
- Ge, Q.X.; Chen, Y.X.; Xu, T. Morphological characteristics and other introduction of Pestalotiopsis clavispora. In Flora Fungorum Sinicorum (Volume 38): Pestalotiopsis; Wei, J.C., Xia, B.M., Hu, Z.Y., Zhuang, W.Y., Wu, P.C., Eds.; Science Press: Beijing, China, 2009; pp. 67–68. [Google Scholar]
- White, T.J.; Bruns, T.; Lee, S.; Taylor, J.W. Amplification and direct sequencing of fungal ribosomal RNA genes for phylogenetics. In PCR Protocols: A Guide to Methods and Applications; Innis, M.A., Gelfand, D.H., Sninsky, J.J., White, T.J., Eds.; Academic Press: Amsterdam, The Netherlands, 1990; pp. 315–322. [Google Scholar]
- O’Donnell, K.; Kistler, H.C.; Cigelnik, E.; Ploetz, R.C. Multiple evolutionary origins of the fungus causing Panama disease of banana: Concordant evidence from nuclear and mitochondrial gene genealogies. Proc. Natl. Acad. Sci. USA 1998, 95, 2044–2049. [Google Scholar] [CrossRef]
- Carbone, I.; Kohn, L.M. A method for designing primer sets for speciation studies in filamentous ascomycetes. Mycologia 1999, 91, 553–556. [Google Scholar] [CrossRef]
- Glass, N.L.; Donaldson, G.C. Development of primer sets designed for use with the PCR to amplify conserved genes from filamentous ascomycetes. Appl. Environ. Microbiol. 1995, 61, 1323–1330. [Google Scholar] [CrossRef]
- Daengsuwan, W.; Wonglom, P.; Arikit, S.; Sunpapao, A. Morphological and molecular identification of Neopestalotiopsis clavispora causing flower blight on Anthurium andraeanum in Thailand. Hortic. Plant J. 2021, 7, 573–578. [Google Scholar] [CrossRef]
- Pornsuriya, C.; Chairin, T.; Thaochan, N.; Narit, T.; Anurag, S. Identification and characterization of Neopestalotiopsis fungi associated with a novel leaf fall disease of rubber trees (Hevea brasiliensis) in Thailand. J. Phytopathol. 2020, 168, 416–427. [Google Scholar] [CrossRef]
- Zhang, L.; Li, X.H.; Zhou, Y.Y.; Tan, G.J.; Zhang, L.X. Identification and characterization of Colletotrichum species associated with Camellia sinensis anthracnose in Anhui province, China. Plant Dis. 2021, 105, 2649–2657. [Google Scholar] [CrossRef]
- Zhao, J.N.; Ma, Z.; Liu, Z.P.; Shang, Q.X.; Zhao, X.Y.; Wei, Y.M. Pestalotiopsis clavispora causing leaf spot on strawberry. J. Mycol. 2016, 35, 114–120. [Google Scholar]
- Zhang, Q.; Li, Y.H.; Zhao, B.; Xu, L.C.; Ma, H.Y.; Wang, M.A. Synthesis and antifungal activity of new butenolide containing methoxyacrylate scaffold. Molecules 2022, 27, 6541. [Google Scholar] [CrossRef] [PubMed]
- Yang, Y.L.; Fang, B.P.; Feng, S.J.; Wang, Z.Y.; Luo, Z.X.; Yao, Z.F.; Zou, H.D.; Huang, L.F. Isolation and identification of Trichoderma asperellum, the novel causal agent of green mold disease in sweetpotato. Plant Dis. 2021, 105, 1711–1718. [Google Scholar] [CrossRef] [PubMed]
- Wang, L.; Wang, N.; Yu, J.L.; Wu, J.; Liu, H.; Lin, K.J.; Zhang, Y.Y. Identification of pathogens causing alfalfa Fusarium Root Rot in Inner Mongolia, China. Agronomy 2023, 13, 456. [Google Scholar] [CrossRef]
- Addrah, E.M.; Zhang, Y.; Zhang, J.; Liu, L.; Zhou, H.Y.; Chen, W.D.; Zhao, J. Fungicide treatments to control seed-borne fungi of sunflower seeds. Pathogens 2019, 9, 29. [Google Scholar] [CrossRef] [PubMed]
- Li, J.L.; Liu, X.Y.; Xie, J.T.; Di, Y.L.; Zhu, F.X. A Comparison of different estimation methods for fungicide ECsub50/sub and ECsub95/sub Values. J. Phytopathol. 2015, 163, 239–244. [Google Scholar] [CrossRef]
- Zhou, Z.H.; Wang, Y.C.; Duan, Y.B.; He, Y.N.; Liu, S.; Chen, Y.; Deng, W.C.; Li, C.P.; Hu, W.J.; Gu, Y.J.; et al. Inhibitory Effect and Control Efficacy of Picoxystrobin against Neopestalotiopsis clavispora, Causing Vine Tea Leaf Blight. Agronomy 2023, 13, 1340. [Google Scholar] [CrossRef]
- Paula, A.; Cristina, A.V.; Victoria, M.; Pedro, M.; Maria, S.A.; Stadnik, M.J. Reclassification of the main causal agent of Glomerella leaf spot on apple into Colletotrichum chrysophilum in southern Brazil and Uruguay. Phytopathology 2022, 112, 1825–1832. [Google Scholar]
- Kumar, A.; Sharma, J. Host plant cultivar, leaf positions and nutrition affect the expression of Marssonina blotch resistance in apple. Plant Dis. Res. 2014, 29, 1–5. [Google Scholar]
- Sofi, A.T.; Beig, A.M.; Dar, H.G.; Ahanger, F.A.; Hamid, A.; Dar, W.A. Disease status of alternaria leaf blotch and evaluation of apple cultivars against Alternaria mali. Plant Dis. Res. 2013, 28, 239. [Google Scholar]
- Sajeewa, S.N.; Maharachchikumbura, S.S.N.; Guo, L.D.; Cai, L.; Chukeatirote, E.; Wu, W.P.; Sun, X.; Pedro, W.C.; Jayarama, B.D.; McKenzie, E.H.C.; et al. A multi-locus backbone tree for Pestalotiopsis, with a polyphasic characterization of 14 new species. Fungal Divers. 2012, 56, 95–129. [Google Scholar]
- Fisher, M.; Henk, D.A.; Briggs, C.J.; Brownstein, J.S.; Madoff, L.C.; McCraw, S.L.; Gurr, S.J. Emerging fungal threats to animal, plant and ecosystem health. Nature. 2012, 484, 186–194. [Google Scholar] [CrossRef] [PubMed]
- Das, R.; Chutia, M.; Das, K.; Jha, D.K. Factors affecting sporulation of Pestalotiopsis disseminata causing grey blight disease of Persea bombycina Kost., the primary food plant of muga silkworm. Crop Prot. 2010, 29, 963–968. [Google Scholar] [CrossRef]
- Jayawardena, R.S.; Zhang, W.H.; Liu, M.H.; Sajeewa, S.N.; Maharachchikumbura, S.S.N.; Zhou, Y.; Huang, J.B.; Nilthong, S.; Wang, Z.Y.; Li, X.H.; et al. Identifification and characterization of Pestalotiopsis-like fungi related to grapevine diseases in China. Fungal Biol. 2015, 119, 348–361. [Google Scholar] [CrossRef] [PubMed]
- Song, L.S. Research on taxonomy, molecular systematics and DNA barcoding of Pestalotiopsis. Ph.D. Thesis, Guangxi University, Nanning, China, 2016. [Google Scholar]
- Solarte, F.; Muñoz, C.G.; Maharachchikumbura, S.S.N.; Álvarez, E. Diversity of Neopestalotiopsis and Pestalotiopsis spp., causal agents of guava scab in Colombia. Plant Dis. 2018, 102, 49–59. [Google Scholar] [CrossRef] [PubMed]
- Reddy, M.S.; Murali, T.S.; Suryanarayanan, T.S.; Govinda, R.; Thirunavukkarasu, N. Pestalotiopsis species occur as generalist endophytes in trees of Western Ghats forests of southern India. Fungal Ecol. 2016, 24, 70–75. [Google Scholar] [CrossRef]
- Cao, Y.; Zhang, S.; Zhang, J.; Wang, Y.J.; Qian, S.J.; Sun, Y.; Yan, X.R. First report of Neopestalotiopsis foedans causing blueberry diseases. Acta Phytopathol. Sin. 2022, 53, 367–374. [Google Scholar]
- Cun, H.C.; He, P.B.; He, P.F.; Wu, Y.X.; Shahzad, M.; Tang, Z.X.; He, Y.Q. Etiology of the pathogen causing brown leaf spot on Rhododendron lapponicum. Mycosystema 2023, 42, 707–718. [Google Scholar]
- Chamorro, M.; Aguado, A.; Santos, B.D. First report of root and crown rot caused by Pestalotiopsis clavispora (Neopestalotiopsis clavispora) on strawberry in Spain. Plant Dis. 2016, 100, 1495. [Google Scholar] [CrossRef]
- Qi, Y.X.; Zhao, H.; Zhang, H. Characterization of Neopestalotiopsis clavispora, a new etiological agent of leaf spot isolated from banana. Plant Dis. Pests 2022, 13, 1–3. [Google Scholar]
- Qi, Y.X.; Zhang, H.; Peng, J.; Zeng, F.Y.; Xie, Y.X.; Yu, Q.F.; Zhang, X. First report of Neopestalotiopsis clavispora causing leaf spot disease on banana (Musa acuminate L.) in China. Plant Dis. 2022, 107, 220. [Google Scholar] [CrossRef]
- Li, K.K.; Zhang, C.L.; Wang, W.X.; Chen, C.Z.; Liu, Q.S.; Yin, H. First report of Neopestalotiopsis clavispora causing postharvest fruit rot on Actinidia arguta in Liaoning Province, China. Plant Dis. 2022, 107, 217. [Google Scholar] [CrossRef] [PubMed]
- Zhu, R.J.; Liu, Y.L.; Li, H.Y.; Liu, J.B.; Han, X.Y. First report of Neopestalotiopsis clavispora causing leaf spots on Garcinia mangostana in China. Plant Dis. 2022, 107, 1946. [Google Scholar] [CrossRef] [PubMed]
- Li, Y.; Zhang, S.Q.; Wang, T.N.; Zhou, S.G.; Wu, Y.; Huang, X.Q.; Lin, H.P.; Su, X. First report of Taxus media branch blight caused by Neopestalotiopsis clavispora in China. Plant Dis. 2022, 106, 3214. [Google Scholar] [CrossRef] [PubMed]
- Espinoza, J.G.; Briceño, E.X.; Keith, L.M.; Latorre, B.A. Canker and twig dieback of blueberry caused by Pestalotiopsis spp. and a Truncatella sp. in Chile. Plant Dis. 2008, 10, 1407–1414. [Google Scholar] [CrossRef] [PubMed]
- Chakkiyanickal, N.B.; Mohammed, F.P.; Rajan, G. Identification and characterization of Neopestalotiopsis clavispora associated with leaf blight of small cardamom (Elettaria cardamomum Maton). J. Phytopathol. 2018, 166, 532–546. [Google Scholar]
- Huo, H.L.; Huangfu, J.R.; Song, P.L.; Zhang, D.M.; Shi, Z.D.; Zhao, L.L.; Li, Z.Q.; Zhou, H.Y. Isolation, identification and characterization of Leptosphaerulina trifolii, the causative agent of alfalfa Leptosphaerulina Leaf spot in Inner Mongolia, China. Agronomy 2024, 14, 1156. [Google Scholar] [CrossRef]
- Sanjay, R.; Ponmurugan, P.; Baby, U.I. Evaluation of fungicides and biocontrol agents against grey blight disease of tea in the field. Crop Prot. 2008, 27, 689–694. [Google Scholar] [CrossRef]
- Saju, K.A.; Mech, S.; Deka, T.; Biswas, A.K. In vitro evaluation of biocontrol agents, botanicals and fungicides against Pestalotiopsis sp. infecting large cardamom (Amomum subulatum Roxb.). J. Spices Aromat. Crops 2011, 20, 89–92. [Google Scholar]
- Zhang, C.Q.; Liu, Y.H.; Wu, H.M.; Xu, B.C.; Sun, P.L.; Xu, Z.H. Baseline sensitivity of Pestalotiopsis microspora, which causes black spot disease on Chinese hickory (Carya cathayensis) to pyraclostrobin. Crop Prot. 2012, 42, 256–259. [Google Scholar] [CrossRef]
- Xue, D.S.; Shao, Z.H.; Li, B.H.; Wang, C.X. Indoor fungicide screening for Pestalotiopsis clavispora of blueberry. Shandong Agric. Sci. 2018, 50, 115–118. [Google Scholar]

| Gene | Primer | Sequence (5′-3′) | Annealing Temperature/°C |
|---|---|---|---|
| ITS | ITS1 | TCCGTAGGTGAACCTGCGG | 53 |
| ITS4 | TCCTCCGCTTATTGATATGC | ||
| TEF1α | EF1-728F | CATCGAGAAGTTCGAGAAGG | 58 |
| EF2 | GGARGTACCAGTSATCATGTT | ||
| TUB2 | Bt2a | GGTAACCAAATCGGTGCTGCTTTC | 59 |
| Bt2b | ACCCTCAGTGTAGTGACCCTTGGC |
| Species | Strain No. | GenBank Accession Numbers | ||
|---|---|---|---|---|
| ITS | TEF1α | TUB2 | ||
| Neopestalotiopsis asiatica | CMF 164 | MN784703 | MN816249 | MN808590 |
| Neopestalotiopsis australis | KNU16-005 | KY398730 | KY398732 | KY398731 |
| Neopestalotiopsis acrostichi | MFLUCC 17-1755 T | MK764273 | MK764317 | MK764339 |
| Neopestalotiopsis brachiata | MFLUCC 17-1555 T | MK764274 | MK764318 | MK764340 |
| Neopestalotiopsis chrysea | LSCKS81 | OQ392362 | OQ410712 | OQ410711 |
| Neopestalotiopsis clavispora | DBNC0627 | MT742640 | MT745889 | MT745888 |
| Neopestalotiopsis cubana | CBS 600.96 T | KM199347 | KM199521 | KM199438 |
| Neopestalotiopsis egyptiaca | CBS H-22294 T | KP943747 | KP943748 | KP943746 |
| Neopestalotiopsis ellipsospora | GZCC 15-0085 T | KU500017 | KU500013 | KU500010 |
| Neopestalotiopsis eucalypticola | CBS 264.37 T | MH855907 | KM199551 | KM199431 |
| Neopestalotiopsis formicarum | CBS 362.72 T | KM199358 | KM199517 | KM199455 |
| Neopestalotiopsis iberica | XF6 | OM333900 | OM350155 | OM350157 |
| Neopestalotiopsis longiappendiculata | CNUCC 25411 | OP168149 | OP183977 | OP183981 |
| Neopestalotiopsis macadamiae | BRIP 63737c T | KX186604 | KX186627 | KX186654 |
| Neopestalotiopsis mesopotamica | CBS 336.86 T | KM199362 | KM199555 | KM199441 |
| Neopestalotiopsis musae | MFLUCC 15-0776 T | KX789683 | KX789685 | KX789686 |
| Neopestalotiopsis petila | MFLUCC 17-1738 T | MK764276 | MK764320 | MK764342 |
| Neopestalotiopsis rosae | JZB340071 | MN495978 | MN968335 | MN968343 |
| Neopestalotiopsis sonneratae | MFLUCC 17-1744 T | MK764279 | MK764323 | MK764345 |
| Neopestalotiopsis zimbabwana | CBS 111495 T | MW422813 | KM199545 | KM199456 |
| Pestalotiopsis trachicarpicola | MFLUCC 12-0266 T | JX399002 | JX399066 | JX399033 |
| Pseudopestalotiopsis cocos | CBS 272.29 T | MH855069 | KM199553 | KM199467 |
| Active Ingredients Name | Commercial Name | Dosage Form | Manufacturer Information |
|---|---|---|---|
| Pylocyanonitrile | Huiyou | 50% WP | Syngenta (China) Investment Co., Ltd., Shanghai, China |
| Diphenoxazole | Jianjingkang | 40% SC | Jiangsu Jianpai Agrochemical Co., Ltd., Yancheng, Jiangsu, China |
| Procymidone | Difenkang | 20% SC | Jiangxi He Yi Chemical Co., Ltd., Jiujiang, Jiangxi, China |
| Pyraclostrobin | Kairun | 250 g/L EC | BASF(China) Co., Ltd., Shanghai, China |
| Propiconazole | Xiute | 250 g/L EC | Syngenta (China) Investment Co., Ltd., Shanghai, China |
| Myclobutanil | Yibaofeng | 40% SC | Jiangxi He Yi Chemical Co., Ltd., Jiujiang, Jiangxi, China |
| Tebuconazole | Haolike | 430 g/L SC | Bayer Crop Science (China) Co., Ltd., Beijing, China |
| Metiram | Pinrun | 70% WG | BASF (China) Co., Ltd., Shanghai, China |
| Osthole | N/A | 1% EW | Inner Mongolia Qingyuanbao Biotechnology Co., Ltd., Bayannur, Inner Mongolia, China |
| Eugenol | Shuanglang | 0.3% SL | Shandong Yijia Agricultural Chemical Co., Ltd., Shouguang, Shandong, China |
| Fruit Name (Scientific Name) | Family | Incubation Period (dpi) | Lesion Diameter (cm) * | Infection Rate (%) * | Infection Status | |
|---|---|---|---|---|---|---|
| SW | NW | |||||
| Crabapple (Malus spectabilis (Ait.) Borkh.) | Rosaceae | 2 | 1.53 ± 0.10 c | 100 ± 0 a | + | − |
| Sweet cherry (Prunus avium L.) | Rosaceae | 2 | 1.81 ± 0.16 b | 100 ± 0 a | + | − |
| Peach (Prunus persica (L.) Batsch) | Rosaceae | 2 | 1.23 ± 0.27 d | 91.67 ± 14.43 ab | + | − |
| Pear (Pyrus communis L.) | Rosaceae | 3 | 1.14 ± 0.18 d | 83.30 ± 14.43 b | + | − |
| Grape (Vitis vinifera L.) | Ampelidaceae | 2 | 2.41 ± 0.28 a | 100 ± 0 a | + | − |
| Active Ingredients Name | Treatment Concentration (µg/mL) | Toxic Regression Equation | EC50 (µg/mL) * | Correlation Coefficient (r) |
|---|---|---|---|---|
| Pylocyanonitrile | 0.039, 0.08, 0.156, 0.313, 0.625, 1.25 | y = 1.3009x + 6.2400 | 0.111 ± 0.082 h | 0.964 |
| Diphenoxazole | 0.391, 0.781, 1.563, 3.125, 6.25, 12.5 | y = 0.7686x + 4.7944 | 1.852 ± 0.076 f | 0.960 |
| Procymidone | 1.25, 5, 10, 20, 80, 160 | y = 1.3080x + 3.3145 | 19.44 ± 0.023 d | 0.998 |
| Tebuconazole | 0.391, 0.781, 1.563, 3.125, 6.25, 12.5 | y = 0.8217x + 4.9012 | 1.319 ± 0.049 fg | 0.981 |
| Pyraclostrobin | 0.195, 0.391, 0.781, 1.563, 3.125, 6.25 | y = 0.6665x + 5.2177 | 0.471 ± 0.020 gh | 0.995 |
| Propiconazole | 0.156, 0.313, 0.625, 1.25, 2.5, 5 | y = 0.9467x + 5.3658 | 0.411 ± 0.028 gh | 0.996 |
| Myclobutanil | 1.25, 20, 40, 80, 160, 320 | y = 1.4343x + 2.2415 | 83.813 ± 0.145 a | 0.957 |
| Metiram | 5, 20, 40, 80, 160, 320 | y = 1.7073x + 2.1938 | 44.017 ± 0.072 b | 0.975 |
| Osthole | 1.25, 2.5, 5, 10, 40, 80 | y = 0.8011x + 4.5333 | 3.824 ± 0.041 e | 0.993 |
| Eugenol | 1.563, 3.125, 6.25, 12.5, 25, 100 | y = 0.8268x + 3.8660 | 23.527 ± 0.058 c | 0.986 |
Disclaimer/Publisher’s Note: The statements, opinions and data contained in all publications are solely those of the individual author(s) and contributor(s) and not of MDPI and/or the editor(s). MDPI and/or the editor(s) disclaim responsibility for any injury to people or property resulting from any ideas, methods, instructions or products referred to in the content. |
© 2024 by the authors. Licensee MDPI, Basel, Switzerland. This article is an open access article distributed under the terms and conditions of the Creative Commons Attribution (CC BY) license (https://creativecommons.org/licenses/by/4.0/).
Share and Cite
Shi, J.; Li, B.; Wang, S.; Zhang, W.; Shang, M.; Wang, Y.; Liu, B. Occurrence of Neopestalotiopsis clavispora Causing Apple Leaf Spot in China. Agronomy 2024, 14, 1658. https://doi.org/10.3390/agronomy14081658
Shi J, Li B, Wang S, Zhang W, Shang M, Wang Y, Liu B. Occurrence of Neopestalotiopsis clavispora Causing Apple Leaf Spot in China. Agronomy. 2024; 14(8):1658. https://doi.org/10.3390/agronomy14081658
Chicago/Turabian StyleShi, Jie, Baoyan Li, Shaoli Wang, Wei Zhang, Mingqing Shang, Yingzi Wang, and Baoyou Liu. 2024. "Occurrence of Neopestalotiopsis clavispora Causing Apple Leaf Spot in China" Agronomy 14, no. 8: 1658. https://doi.org/10.3390/agronomy14081658
APA StyleShi, J., Li, B., Wang, S., Zhang, W., Shang, M., Wang, Y., & Liu, B. (2024). Occurrence of Neopestalotiopsis clavispora Causing Apple Leaf Spot in China. Agronomy, 14(8), 1658. https://doi.org/10.3390/agronomy14081658






